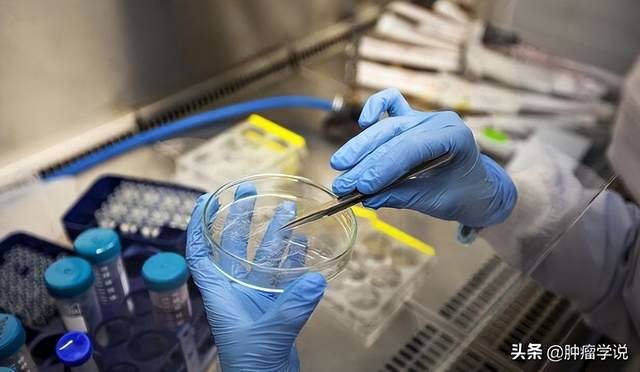

肝转移是结直肠癌患者最主要的死亡原因。2022年国家癌症中心发布我国癌症发病最新数据,其中结直肠癌的新发病例和死亡病例分别位列所有瘤种的第2位和第4位。

肝脏是结直肠癌血行转移最主要的靶器官,中国结直肠癌患者中43.8%在确诊时即合并转移,其中肝转移占比超过半数,而另有8.1%~12.8%患者在结直肠癌原发灶根治术后可发生肝转移,其中绝大多数的肝转移灶初始无法获得根治性切除。
很多患者认为,直肠癌出现转移,基本就已经没指望了,不如放弃治疗。但其实,对于结直肠癌来说,这个观点并不正确。
结直肠癌发生了肝转移就无法治愈了?
传统的观念认为,结直肠癌一旦发生肝转移,已经属于晚期,生存时间不多,手术治疗已经不再有价值。其实,这是一个普遍存在的认识误区!
20年代80世纪初,,世界卫生组织WHO明确提出了3个“1/3”的观点。即1/3的癌症可以预防,1/3的癌症可以治愈,1/3 的癌症可以提高其患者生存质量,延长寿命。癌症并不等于死亡,少数癌症会自愈,不少晚期癌症患者接受治疗后仍然可以实现带癌长期生存。
“带瘤生存”是指病人经过全身有效的抗肿瘤治疗后,常见的癌性症状消失,病人一般状况良好,可独立工作和生活,换言之机体免疫保护功能大于肿瘤扩散能力,使癌细胞长期"静止"、"休眠",病人处于临床治愈的健康状态。"
如果癌细胞能控制为不再增长、不侵袭不转移的细胞,即使体内有癌细胞,也可以像糖尿病、高血压一样长期生存。带瘤生存"是中晚期癌症病人得以长期存活的出路,也是现在科研主攻方向。
免疫细胞疗法,实现晚期癌症“带瘤生存”
癌症治疗一直立足于手术、放疗和化疗传统3大疗法。在过去30年的癌症治疗的临床实践中,相关医学人员研发出无毒微副作用的癌症治疗的模式,免疫细胞治疗已经被增加为癌症治疗的一个重要组成部分。
免疫治疗出现以前,肺癌治疗手段主要包括手术、放疗、化疗和靶向治疗。早期癌症可以通过手术进行治疗,预后良好,很多患者可望治愈。但由于癌症在早期症状不明显,大多数患者在确诊时已为晚期,只能通过治疗控制疾病进展,延长患者的生存时间,改善患者生活质量。目前,免疫治疗成为帮助晚期癌症患者实现“带瘤生存”的方法。
免疫细胞治疗,通过增殖、增强并激活癌症患者的免疫细胞,控制癌肿发展,改善患者体内肿瘤微环境,调整免疫系统功能及各细胞因子的水平从而抑制肿瘤发展,诱导癌细胞凋。
比如说NK(Natural Killer Cell)免疫细胞疗法,就是将我们体内的NK细胞随血液抽取,体外扩增培养,使其数量大量增加(一般是由数百万扩增至数十亿),回输之后NK细胞会随着血液不断循环来对身体当中形成的癌细胞进行杀灭。还有DC-CIK细胞疗法。DC细胞又称作树突状细胞,是我们体内抗原辞呈能力最强的细胞。
CIK细胞又称作细胞因子诱导肿瘤杀伤细胞,这种细胞是将体内的单个核细胞在体外进行修饰、刺激、培养、增殖之后形成的,兼有T细胞和NK细胞的特性。所以DC-CIK细胞的特性是聪识别肿瘤抗原并把信息传递给CIK细胞,然后CIK通过发挥自身细胞毒性和分泌细胞因子杀伤肿瘤,从而完成了辨别敌人到杀灭敌人的全过程。
越来越多优秀的免疫细胞疗法已经出现,且已经有大量事实案例证实,免疫疗法要优于现在传统的癌症治疗手段,如手术、放疗和化疗。至少,相比手术,它不需要术后愈合。相比放疗和化疗,它对于我们的健康细胞并没有什么危害。
因此对于肝转移但不适合立即手术的患者,通过免疫治疗联合治疗是有可能可以帮助患者重获手术机会。据日本数据统计,现在已经有80%左右的患者,可以通过免疫联合治疗让癌症病灶的大小减半,从而帮助更多患者重获手术机会。此外存在远端转移的IV期结直肠癌患者的5年生存率提高到了20%-30%。这也让越来越多的结直肠癌患者跨越了5年生存期,实现了更长的生存获益。
长期生存是每一位癌症患者的迫切诉求,很多患者家属认为,结直肠癌一旦出现肝转移就意味着“晚期”,已失去再治疗的意义了,但其实转移后患者通过正确治疗,仍然可以延长生存期,提高患者的预后。
现在癌症与死亡不再简单地划等号,最新的癌症治疗理念已经从带癌生存转为带癌生活,与癌共舞。几十年来的科学进步带来的结果是:癌症已经成为一种可控制,甚至可治愈的疾病,患者的生存率达到了一个新高度。
如今的癌症治疗已经进入免疫细胞治疗时代,多个临床结果证明,细胞免疫疗法可以为患者带来更多的生存益处,在启动特异性、主动性的重要自体免疫细胞,可直接标靶性地攻击与破坏手术后残留之特定癌细胞,进而提高疗效,并缓和手术后如放疗和化疗带来的毒副作用,有效延长病人生命的同时,提高病人生存期的生活质量。